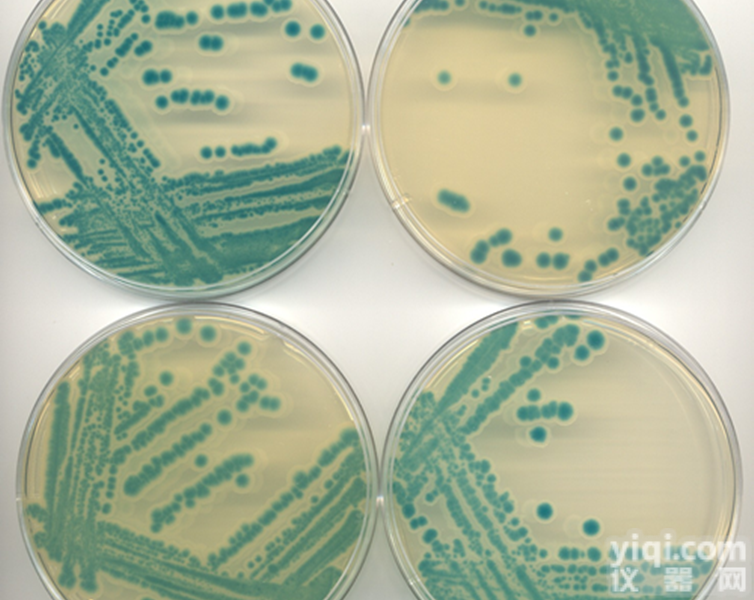
<em>百日咳</em>  <em>百日咳</em>毒素<em>抗体</em>检测试剂

大鼠百日咳病毒IgA抗体(PT-IgA)elisa试剂盒/大鼠百日咳病毒IgA抗体(PT-IgA)
- 品牌:elabscience
- 型号:E-EL-R0726km
- 产地:中国
- 供应商:上海恒斐生物科技有限公司
- 供应商报价:¥2200
- 标签:大鼠百日咳病毒IgA抗体(PT-IgA)elisa试剂盒/大鼠百日咳病毒IgA抗体(PT-IgA)、大鼠百日咳病毒IgA抗体(PT-IgA)elisa试剂盒/大鼠百日咳病毒IgA抗体(PT-IgA)价格、大鼠百日咳病毒IgA抗体(PT-IgA)elisa试剂盒/大鼠百日咳病毒IgA抗体(PT-IgA)厂家、、、上海恒斐生物科技有限公司